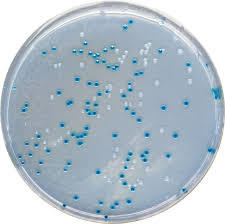
培地学シリーズ17 - 食品細菌自動検査システムの株式会社 バイオ・シータ

坂崎利一著 新細菌培地学講座・上 Amazon.co.jp: 新細菌培地学講座 (上) : 坂崎 利一: Japanese Books
(4083件)
Pontaパス特典
サンキュー配送
6375円(税込)
64ポイント(1%)
Pontaパス会員ならさらに+1%ポイント還元!
送料
(
)
4082
配送情報
お届け予定日:2026.05.09 7:43までにお届け
※一部地域・離島につきましては、表示のお届け予定日期間内にお届けできない場合があります。
ロットナンバー
1410496280
お買い物の前にチェック!

Pontaパス会員なら
ポイント+1%
ポイント+1%
商品説明



書名:新 細菌培地学講座・上初版:1978年1月30日著者:坂崎利一発行:株式会社近代出版 1981年11月に発行された初版第四刷です。細菌の性状検査の入門・実用書として細菌微生物に携わってこられた方々に長年読みつがれている書籍の初版本です。改訂版含めて既に絶版となっておりますので、新規での入手は困難です。経年劣化により焼け、擦れがありますが状態は悪くないと思います。#坂崎利一
| カテゴリー: | 本・雑誌・漫画>>>本>>>健康・医学 |
|---|---|
| 商品の状態: | 傷や汚れあり","多くの人が見てわかるような傷や汚れがある |
| 配送料の負担: | 送料込み(出品者負担) |
| 配送の方法: | 佐川急便/日本郵便 |
| 発送元の地域: | 神奈川県 |
| 発送までの日数: | 1~2日で発送 |
レビュー
商品の評価:




 4.4点(4083件)
4.4点(4083件)
- ぴよぴよ007
- 30年以上前の自分が子供のころの大好きな本を3歳の娘に買ってみました。ついでにシリーズ全部買ってみました。やっぱり楽しい本です。
- 55まめぞう
- 30年以上前の自分が子供のころの大好きな本を3歳の娘に買ってみました。ついでにシリーズ全部買ってみました。やっぱり楽しい本です。
- なし19542429
- ちくわのわーさんが子供が気に入ったので、うどんも購入です。 喜んでもらえるといいな。
- y2990a2660
- 立体ぬりえワークブックって何かなぁ・・・?って買ってみたら。プラモデルまでは出来ない、小さい子供もこれなら自分で作れました。作って作品に色を塗って楽しそうでした。どんどんシリーズを増やして欲しい。
- naokozu3080
- 地元の書店で探してもどこも欠品中で何気なくこちらで検索したら 在庫ありだったので即購入しました。 メール便でしたがすぐに届きました。 子供も好きですが、母親が好きで 毎日読んでいるそうです。 買った甲斐がありました。
- 水玉パンツ
- 最近電車好きな息子のために購入しました。毎日嬉しそうに眺めています。買ってよかったです。 注文番号 213310-20120531-061272813
- ブラックバード840
- 楽天POINTがたまり娘に何か買ってあげたいと思い 悩んだのですが「モグラバス」が好きなこともあり それと同じなのでこれにしました。楽しそうに読んでいて良かったです。 娘が6歳の時に買いました
- あめだまさん
- 毎晩、子供にベットで読まされています!!
- まちゃぷー
- 大判サイズでとてもいいです。ディズニーキャラ満載で、めくる度にぱりぱりと音がして、大喜び。飽きずに齧ったり、めくったりしてます。
- 愚かの極み
- 次の日に来ました。息子もよろこんで読んでいます。 有難うございました。
- 港のK
- チリとチリリの本が素敵だったので、シリーズ全部そろえました。どの本もとてもかわいいので、親子で毎日読んでいます。 機会があれば、友達にもプレゼントしたいぐらいです。
- みぃ8979
- 友人の出産祝いにしました。 5歳のお姉さんがいる家だったのですが その子もすごく喜んでくれました。
- よっちゃん2829
- 会社の人の出産祝いとして買いました。喜んでもらえました。
すべて見る
お店の情報
7,367
連絡・応対
4.3
配送スピード
4.3
梱包
4.3